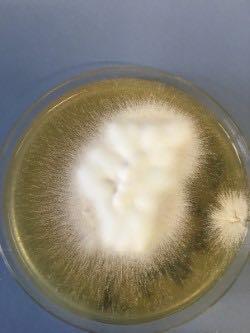

Speziallabor für Dermatologische Infektionsdiagnostik

Leitung: Dr. med. univ. N. Janjic
Mykologische und mikrobiologische Diagnostik
Präzision, die Vertrauen schafft – moderne Verfahren zur Erregeridentifikation
bei kutanen und sexuell übertragbaren Infektionen
Diagnostische Verfahren
Präzision in der Mykologie – moderne Diagnostik dermatologischer Infektionen
In unserem spezialisierten mikrobiologischen Labor bieten wir ein umfassendes Spek- trum an diagnostischen Verfahren zur Identifikation kutaner Infektionserreger. Durch die Kombination klassischer und moderner Technologien ermöglichen wir eine schnelle, prä-zise und klinisch relevante Erregerdiagnostik – insbesondere bei Dermatomykosen und anderen hautassoziierten Infektionen sowie sexuell übertragbaren Erkrankungen (STI).
Unsere diagnostischen Leistungen umfassen folgende Verfahren:
1. Direktmikroskopie von Nativpräparaten
Die Direktmikroskopie stellt ein schnelles und bewährtes Verfahren zur Erkennung pilzassoziierter Strukturen dar. Mittels Nativpräparaten von Hautschuppen, Haaren oder Nagelmaterial lassen sich nach Aufbereitung typische morphologischen Merkmale von Dermatophyten, Hefepilzen (Candida spp), Malassezia furfur sowie die Haarbalgmilde Demodex folliculorum nachweisen.
Diese Methode liefert binnen Minuten eine erste mykologischen Einschätzung – essenziell für die klinische (Primär-)Diagnostik.
Die kulturelle Anzucht ist eine Methode zur genaueren Charakterisierung von Dermatophyten, Hefen und Schimmelpilzen aus Hautschuppen, Haaren, Nagelmaterial und Schleimhautabstrichen. Diese werden auf ein spezifischen Nährmedium aufgebracht und über mehrere Tage bis Wochen bebrütet.
3. Molekularbiologische Erregeridentifikation mittels Pilz-PCR
Die Polymerase-Kettenreaktion (PCR) ergänzt unser diagnostisches Portfolio durch ihre hohe Sensitivität und Spezifität – besonders bei schwer kultivierbaren oder atypischen Pilzinfektionen. Sie ermöglicht den direkten Nachweis von Pilz-DNA aus klinischem Probenmaterial, selbst dann, wenn weder Mikroskopie noch Kultur anschlagen bzw. negativ sind.
Die PCR-basierte Diagnostik schafft die Grundlage für eine individualisierte, zielgerichtete antimykotische Therapie – im Einklang mit den aktuellen nationalen (Deutschsprachigen Mykologischen Gesellschaft (DMykG)) sowie internationalen Leitlinien.
Zielgerichtete molekularbiologische Erregeridentifikation bei sexuell übertragebaren Infektionen:
Im Rahmen einer modernen STI-Diagnostik bieten wir eine schnelle, hochsensitive und spezifische molekularbiologische Analyse mehrerer Pathogene aus einer Probe mittels Multiplex-PCR an.
Ein direkter DNA-Nachweis pathogener Mikroorganismen aus Abstrichen wie z. B. der Urethra, Zervix, dem Rektum und Pharynx wird dabei gewonnen.
Nachweisbare Erkrankungen:
• Chlamydieninfektionen (z. B. Urethritis, Zervizitis, Proktitis)
• Syphilis (Lues) durch T. pallidum
• Gonorrhö (Tripper) durch N. gonorrhoeae
• Genitalherpes durch HSV-1 und HSV-2
• Mycoplasmen- und Ureaplasmen-Infektionen der Harn- und Genitalorgane
• Ulcus molle (weicher Schanker) durch H. ducreyi
• Trichomoniasis
Die hohe Sensitivität und Spezifität der PCR erlaubt auch den Nachweis von asymptomatischen (stillen) und subklinischen Infektionen. Sie bildet damit die Grundlage für eine gezielte antimikrobielle oder antivirale Therapie sowie gegebenenfalls eine Partnerbehandlung zur Vermeidung von Reinfektionen und Spätfolgen.
Unser Anspruch:
Wir arbeiten nach den Standards der Deutschsprachigen Mykologischen Gesellschaft (DMykG) und aktueller mikrobiologischer STI-Leitlinien. Unsere Diagnostik verbindet wissenschaftliche Exzellenz mit klinischer Relevanz – im Dienst einer evidenzbasierten, präzisen Patientenversorgung.
Ablauf Mykologie- und STI-Befundung
• Testkit anfordern
• Probe entnehmen & einsenden
• Diagnostikstart direkt nach Eingang
• Rückfragen bzw. Kontakt und Bestellungen jederzeit möglich
unter:


